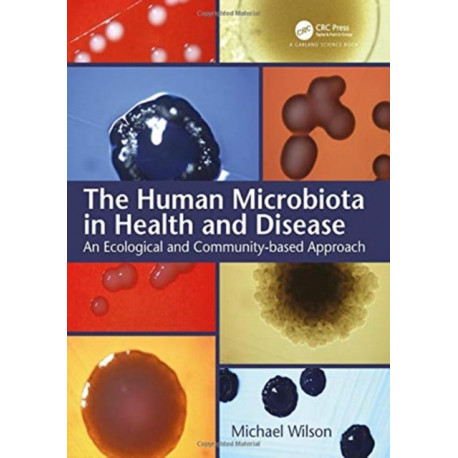
The Human Microbiota in Health and Disease: An Ecological and Community-based Approach

Kurv
Vare
varer
(tom)
Ingen varer
Fastlægges senere
Forsendelse
0,- kr
I alt
The Human Microbiota in Health and Disease: An Ecological and Community-based Approach
(Bog, Hardback, Engelsk)
Forlag:
Taylor & Francis Ltd
- Type: Bog
- Format: Hardback
-
Sprog:
Engelsk

- ISBN-13: 9781138342781
- Se flere detaljer ▼
Bemærk: Kan ikke leveres før jul.
Formater og udgaver
Beskrivelse
This book describes the various microbial communities (microbiota) inhabiting humans as well as their important roles in human health and disease. An ecological approach has been adopted throughout the book to explain why the microbial community at a particular body site has a particular composition when in balance with the host (eubiosis).
Læsernes anmeldelser (0)
Alle detaljer
| Forlag | Taylor & Francis Ltd |
| Forfatter | Mike (University College London) Wilson |
| Type | Bog |
| Format | Hardback |
| Sprog | Engelsk |
| Udgivelsesdato | 07-09-2018 |
| Første udgivelsesår | 2018 |
| Illustrationer | 102 Tables, color; 223 Line drawings, color; 168 Halftones, color; 43 Halftones, black and white; 536 Illustrations, color |
| Originalsprog | United Kingdom |
| Sideantal | 472 |
| Indbinding | Hardback |
| Forlag | Taylor & Francis Ltd |
| Sideoplysninger | 472 pages, 102 Tables, color; 223 Line drawings, color; 168 Halftones, color; 43 Halftones, black an |
| Mål | 276 x 219 |
| ISBN-13 / EAN-13 | 9781138342781 |

